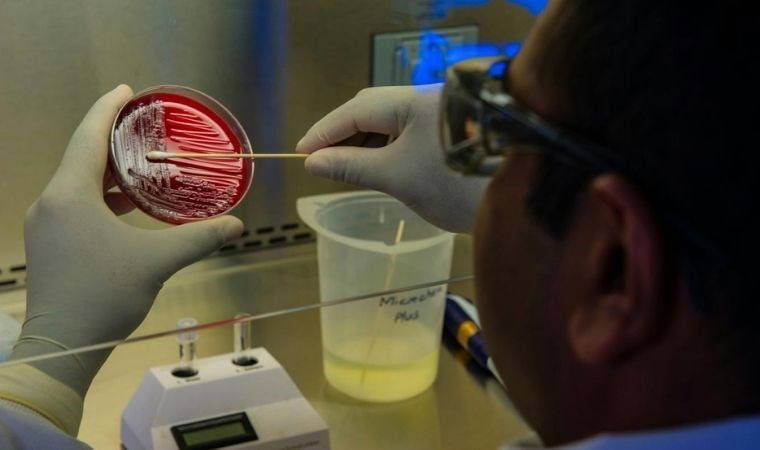
Tedavisi imkansız süper bakteri yayılmaya başladı

Doğru bilinen yanlışlar: Pişirmeden önce asla yıkamamanız gereken 5 yiyecek
Mutfakta hijyen, sağlıklı yemeklerin temel taşıdır. Ancak bazı alışkanlıklar, doğru gibi görünse de beklenmedik riskler doğurabilir. Özellikle gıdaları pişirmeden önce yıkamak, düşündüğünüzün aksine zararlı mikroorganizmaların yayılmasına veya yiyeceklerin doğal dokusunun bozulmasına neden olabilir.
Doğru bilinen yanlışlar: Pişirmeden önce asla yıkamamanız gereken 5 yiyecek
Mutfakta hijyen, sağlıklı yemeklerin temel taşıdır. Ancak bazı alışkanlıklar, doğru gibi görünse de beklenmedik riskler doğurabilir. Özellikle gıdaları pişirmeden önce yıkamak, düşündüğünüzün aksine zararlı mikroorganizmaların yayılmasına veya yiyeceklerin doğal dokusunun bozulmasına neden olabilir.
Tedavisi imkansız süper bakteri yayılmaya başladı
Bilim insanları, savaştan zarar gören Ukrayna'da birçok ilaca direnç gösteren "aşırı patojenik" bakterilerin endişe verici artışa dair uyarıda bulundu.
Tedavisi imkansız süper bakteri yayılmaya başladı
Bilim insanları, savaştan zarar gören Ukrayna'da birçok ilaca direnç gösteren "aşırı patojenik" bakterilerin endişe verici artışa dair uyarıda bulundu.
 Bakteriler de kuşlar gibi mevsim değişimine göre hazırlık yapıyor
Bakterilerin mevsimlerin değiştiğini önceden sezerek hazırlık yaptığı ortaya çıktı.
Bakteriler de kuşlar gibi mevsim değişimine göre hazırlık yapıyor
Bakterilerin mevsimlerin değiştiğini önceden sezerek hazırlık yaptığı ortaya çıktı.
 'Radyasyona dirençli bakteri sürülerine...'
İspanya’da yapılan bir çalışma, mikrodalga fırınlarda yüzlerce bakteri türü bulunduğunu ve bunların bazılarının insan sağlığı için risk oluşturabileceğini gösterdi.
'Radyasyona dirençli bakteri sürülerine...'
İspanya’da yapılan bir çalışma, mikrodalga fırınlarda yüzlerce bakteri türü bulunduğunu ve bunların bazılarının insan sağlığı için risk oluşturabileceğini gösterdi.
 Bakteriler, Dünya'da görülmemiş türlere dönüşüyor
Uluslararası Uzay İstasyonu'nda bakteriler yaşıyor ancak bu bakterilerin mutasyona uğrayarak Dünya'da hiç görülmemiş bir şeye dönüşme yetenekleri şaşırtıyor.
Bakteriler, Dünya'da görülmemiş türlere dönüşüyor
Uluslararası Uzay İstasyonu'nda bakteriler yaşıyor ancak bu bakterilerin mutasyona uğrayarak Dünya'da hiç görülmemiş bir şeye dönüşme yetenekleri şaşırtıyor.
 Bilim insanları: ''Dünya dışı yaşamın yeni rehberi olabilir''
Bilim insanları, fotosentezle kendi besinlerini üretebilen mor bakterilerin, Dünya dışı yaşamın yeni rehberi olabileceğine inanıyor.
Bilim insanları: ''Dünya dışı yaşamın yeni rehberi olabilir''
Bilim insanları, fotosentezle kendi besinlerini üretebilen mor bakterilerin, Dünya dışı yaşamın yeni rehberi olabileceğine inanıyor.
 İdrar yolları enfeksiyonu nedir, nasıl geçer? İdrar yolu enfeksiyonuna ne iyi gelir? Evde doğal yollarla idrar yolu iltihabına çözüm üretilir mi?
Birçok enfeksiyon şekilleri varken idrar yolları enfeksiyonu da tehlikeli bir rahatsızlıktır. Gündemde olan idrar yolu enfeksiyonun ne olduğu ve nasıl anlaşıldığı araştırma konusu oldu. Peki, İdrar yolları enfeksiyonu nedir, nasıl geçer? İdrar yolu enfeksiyonuna ne iyi gelir? Evde doğal yollarla idrar yolu iltihabına çözüm üretilir mi?
İdrar yolları enfeksiyonu nedir, nasıl geçer? İdrar yolu enfeksiyonuna ne iyi gelir? Evde doğal yollarla idrar yolu iltihabına çözüm üretilir mi?
Birçok enfeksiyon şekilleri varken idrar yolları enfeksiyonu da tehlikeli bir rahatsızlıktır. Gündemde olan idrar yolu enfeksiyonun ne olduğu ve nasıl anlaşıldığı araştırma konusu oldu. Peki, İdrar yolları enfeksiyonu nedir, nasıl geçer? İdrar yolu enfeksiyonuna ne iyi gelir? Evde doğal yollarla idrar yolu iltihabına çözüm üretilir mi?
 Bilim insanı paranın üzerindeki 'bakterileri' ortaya çıkarttı
Bilim insanı kişisel eşyalarımızda hangi mikropların gizlendiğine ışık tutan videoları ile bakterilerin gizli dünyasını ortaya çıkarıyor.
Bilim insanı paranın üzerindeki 'bakterileri' ortaya çıkarttı
Bilim insanı kişisel eşyalarımızda hangi mikropların gizlendiğine ışık tutan videoları ile bakterilerin gizli dünyasını ortaya çıkarıyor.
 Uzmanından uyarı: 'Beta, damlacık yoluyla bulaşıyor'
Çocuk Sağlığı ve Hastalıkları Uzmanı Dr. Başak Tanır, beta bakterisinin bulaşıcı olduğunu belirterek, "Bebek ve çocuklara yakın temastan ve kapalı ortamlardan kaçınmak, maske kullanmak gerekiyor" diye konuştu.
Uzmanından uyarı: 'Beta, damlacık yoluyla bulaşıyor'
Çocuk Sağlığı ve Hastalıkları Uzmanı Dr. Başak Tanır, beta bakterisinin bulaşıcı olduğunu belirterek, "Bebek ve çocuklara yakın temastan ve kapalı ortamlardan kaçınmak, maske kullanmak gerekiyor" diye konuştu.
 Evin havasını kirleten ısıtıcılar sağlığı tehdit ediyor
Kış aylarında kapalı ortamda çocukları bekleyen tehlikelere karşı ebeveynleri uyaran Doç. Dr. Hikmet Tekin Nacaroğlu, "Evde hava kirleticiler arasında; ocak ve fırınlardan kaynaklanan yanma kaynaklı emisyonlar, gaz veya gaz yakıtı ile çalışan ısıtıcılar, odun sobası veya şömineler, kül, pişirme kokuları, küf sporları, duş buharı, tütün ürünleri dumanı bulunur" dedi.
Evin havasını kirleten ısıtıcılar sağlığı tehdit ediyor
Kış aylarında kapalı ortamda çocukları bekleyen tehlikelere karşı ebeveynleri uyaran Doç. Dr. Hikmet Tekin Nacaroğlu, "Evde hava kirleticiler arasında; ocak ve fırınlardan kaynaklanan yanma kaynaklı emisyonlar, gaz veya gaz yakıtı ile çalışan ısıtıcılar, odun sobası veya şömineler, kül, pişirme kokuları, küf sporları, duş buharı, tütün ürünleri dumanı bulunur" dedi.
 İngiltere'de altı çocuk 'Strep A bakterisi' nedeniyle öldü
İngiltere'de eylül ayından bu yana altı çocuk Strep A enfeksiyonu nedeniyle öldü. Bu çocuklardan beş tanesi 10 yaşın altında. Peki Strep A bakterisi nedir, hangi hastalıklara yol açar?
İngiltere'de altı çocuk 'Strep A bakterisi' nedeniyle öldü
İngiltere'de eylül ayından bu yana altı çocuk Strep A enfeksiyonu nedeniyle öldü. Bu çocuklardan beş tanesi 10 yaşın altında. Peki Strep A bakterisi nedir, hangi hastalıklara yol açar?
 Cüzzam bakterisi karaciğeri büyütüp yenileyebilir
Cüzzam hastalığı, dünyanın en eski ve en inatçı hastalıklarından biri. Cüzzama sebep olan bakteriler, bir organı yenileme kabiliyeti de taşıyor olabilir.
Cüzzam bakterisi karaciğeri büyütüp yenileyebilir
Cüzzam hastalığı, dünyanın en eski ve en inatçı hastalıklarından biri. Cüzzama sebep olan bakteriler, bir organı yenileme kabiliyeti de taşıyor olabilir.
 50 yıllık gizem çözüldü! Bakteriler nasıl hareket ediyor?
Virginia Üniversitesi Tıp Fakültesindeki araştırmacılar E. coli ve diğer bakterilerin nasıl hareket edebildiğini ortaya çıkarıp onlarca yıllık bir gizemi çözdü.
50 yıllık gizem çözüldü! Bakteriler nasıl hareket ediyor?
Virginia Üniversitesi Tıp Fakültesindeki araştırmacılar E. coli ve diğer bakterilerin nasıl hareket edebildiğini ortaya çıkarıp onlarca yıllık bir gizemi çözdü.





















